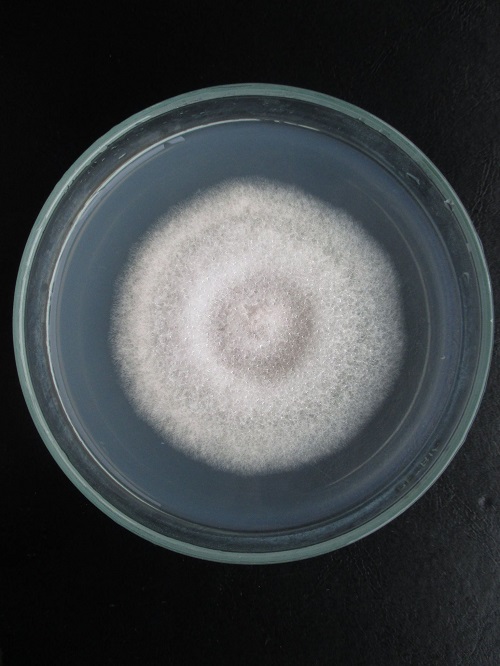

Cà chua là một loại thực phẩm giàu chất dinh dưỡng. Cà chua chứa nhiều vitamin A, C, K, B6, kali, folate, vitamin, magie, niacin, đồng và photpho, tất cả đều là những vi chất dinh dưỡng quan trọng cho sức khỏe tối ưu. Cà chua hiện đang là cây trồng mang lại hiệu quả kinh tế cho người sản xuất. Sâu bệnh đang tàn phá cà chua khi quy mô và diện tích canh tác ngày càng lớn. Thán thư là một loại bệnh lan rộng tàn phá cà chua. Hãy cùng phanthuocvisinh.com tìm hiểu về bệnh thán thư cà chua và cách phòng trị loại bệnh này trong bài viết dưới đây.

Bệnh thán thư cà chua và cách phòng trị
Contents
Bệnh thán thư trên cà chua do nấm Colletotrichum phomoides gây ra và có thể khó xác định. Chúng có dạng hình trụ, đầu tròn và thường không màu.
Nấm Colletotrichum phomoides gây bệnh thán thư cà chua
Bệnh thường phát sinh vào mùa mưa, khi độ ẩm không khí cao, hoặc khi nông dân tưới quá mức cho vườn cà chua (trang trại) của họ. Loại nấm này chủ yếu gây hại cho quả đã chín hoặc đang chín, mặc dù nó cũng có thể gây hại cho quả già.
Ở những nơi, mùa mưa là điều kiện thuận lợi nhất để bệnh thán thư phát sinh và lây lan nhanh chóng. Khi độ ẩm không khí cao, đặc biệt là người trồng đã tưới nhưng nước không bốc hơi hết thì loại nấm này sẽ sinh sôi nảy nở trong đất.
Nấm phát triển nhanh chóng ở nhiệt độ từ 25 đến 30 độ C và lây lan sang các cây lân cận theo gió hoặc dụng cụ làm vườn của nông dân.
Bệnh thán thư trên cà chua phát triển và lây lan nhanh, gây thiệt hại đáng kể cho nông dân mỗi khi vào vụ cà chua. Vì vậy, làm thế nào để có thể nhận biết sớm căn bệnh này? Hãy cùng nhau tìm hiểu.

Vết bệnh thán thư cà chua trên lá
Lá cà chua là nơi đơn giản nhất để phát hiện cây có bị nhiễm bệnh thán thư hay không. Khi chú ý quan sát, chúng ta có thể thấy những đốm nhỏ màu nâu hoặc đen hình tròn trên lá. Không chỉ vậy, nấm còn có thể gây hại cho các cành mới ra hoa của cây, làm thối ngọn và cuối cùng dẫn đến cây chết hoặc cho quả kém chất lượng.
Nấm thích tấn công vào thân cây cà chua trước, thể hiện qua những vết cháy màu nâu sẫm trên thân. Nấm sẽ nhanh chóng lây lan trên toàn bộ thân cây cà chua trong điều kiện nóng ẩm, mưa nhiều hoặc nếu người ta tưới nước thường xuyên.

Bệnh thán thư cà chua trên quả
Loại nấm này sẽ gây ảnh hưởng lớn nhất đến quả cà chua. Sẽ có các mảng hình tròn, hơi lõm vào màu nâu đen, trên hình tròn màu xanh lá cây đỏ. Cuối cùng nó sẽ phát triển thành các vòng lớn hơn. Các vòng đồng tâm và các đốm nhỏ sẽ nhô ra dần dần từ các tổn thương. Sau một thời gian, các vết bệnh ngày càng lớn và làm cho cà chua của chúng ta khô héo, thối rữa và vô giá trị.
Khi bị bệnh tấn công, nó có nhiều tác động xấu đến thân, cành, lá, quả và rất khó phục hồi như ban đầu. Do đó, các chuyên gia nông nghiệp khuyến cáo rằng cần ngăn ngừa bệnh tật trước, trong và sau mỗi vụ mùa bằng cách sử dụng phương pháp thích hợp.

Cách phòng bệnh thán thư trên cà chua
– Khâu chọn giống trước khi trồng ảnh hưởng đến 50% chất lượng của quả. Bà con nên chọn những cây giống ít bệnh, giống đủ tiêu chuẩn từ những nguồn uy tín.
– Để loại bỏ nhiễm trùng, đất nên được xử lý bằng Trichoderma, sau đó kết hợp với phân hữu cơ để cung cấp chất dinh dưỡng cho cây phát triển tối ưu.
– Hạn chế tưới nước vào ban đêm để tránh tạo điều kiện cho nấm bệnh phát triển.
– Cần duy trì mật độ trồng và tạo bầu không khí có lợi cho cây phát triển nhanh. Để ngăn chặn sâu bệnh sinh sôi, vườn phải có hệ thống thoát nước.
– Thường xuyên thăm vườn để theo dõi, kiểm soát sự phát triển của cây nhằm phát hiện kịp thời những bất thường.
– Nếu bạn phát hiện một cây bị nhiễm bệnh trong vườn của bạn, hãy chặt nó, thu gom và loại bỏ nó xa vườn để ngăn ngừa nấm lây lan sang các cây khỏe mạnh khác.
Để giảm bớt thiệt hại của bệnh thán thư trên cây cà chua và mang lại năng suất cao cho nông dân, bệnh này phải được xử lý triệt để. Khi phát hiện bất kỳ dấu hiệu nào của bệnh thán thư trong quá trình sinh trưởng của cây, điều quan trọng là phải sử dụng thuốc để điều trị tận gốc bệnh này càng sớm càng tốt trước khi nó lây lan sang các cây lân cận.
Khuyến cáo cá nhân áp dụng loại thuốc AT Vaccino vừa đơn giản lại cho hiệu quả tức thì giúp cây phục hồi và phát triển trở lại, đảm bảo đầu ra trái cho bà con.
Hy vọng qua bài viết dưới đây, bà con đã hiểu rõ hơn về bệnh thán thư trên cà chua. Để mua thuốc trị thán thư trên cây cà chua, vui lòng liên hệ với CÔNG TY TNHH CÔNG NGHỆ SẠCH NÔNG NGHIỆP qua hotline 09622 41 635.
Giỏ hàng của bạn hiện tại chưa có sản phẩm nào.